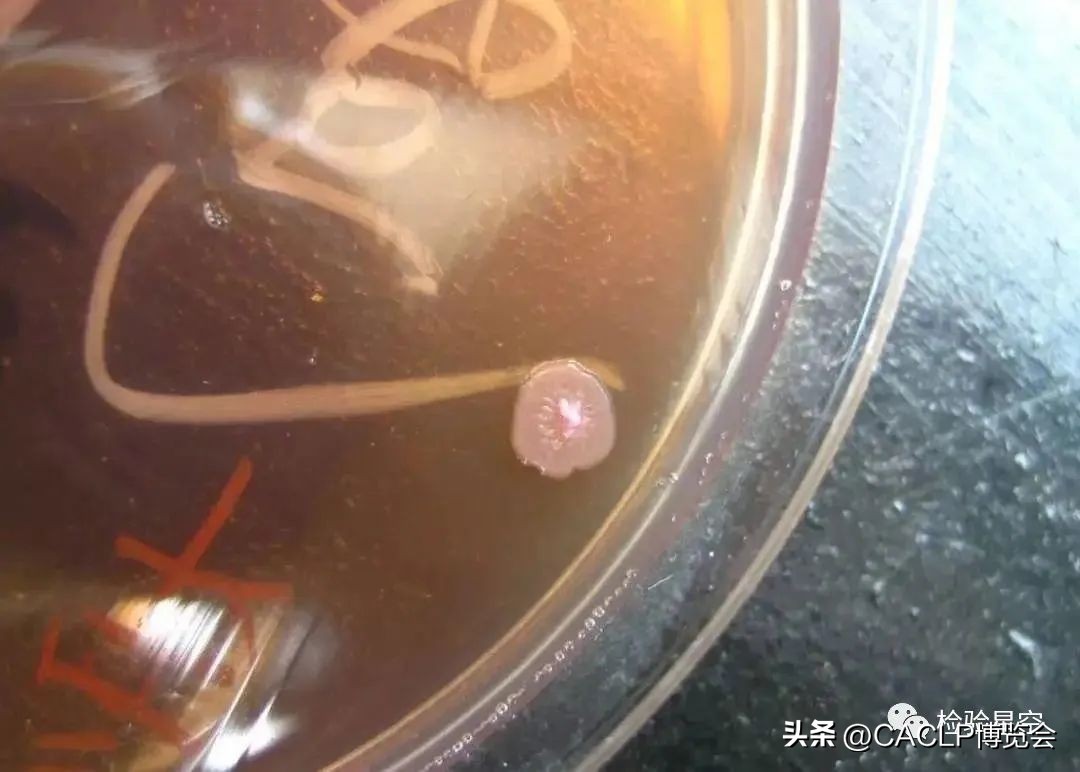
2017版医疗器械分类目录对照表,17年医疗器械分类目录21类
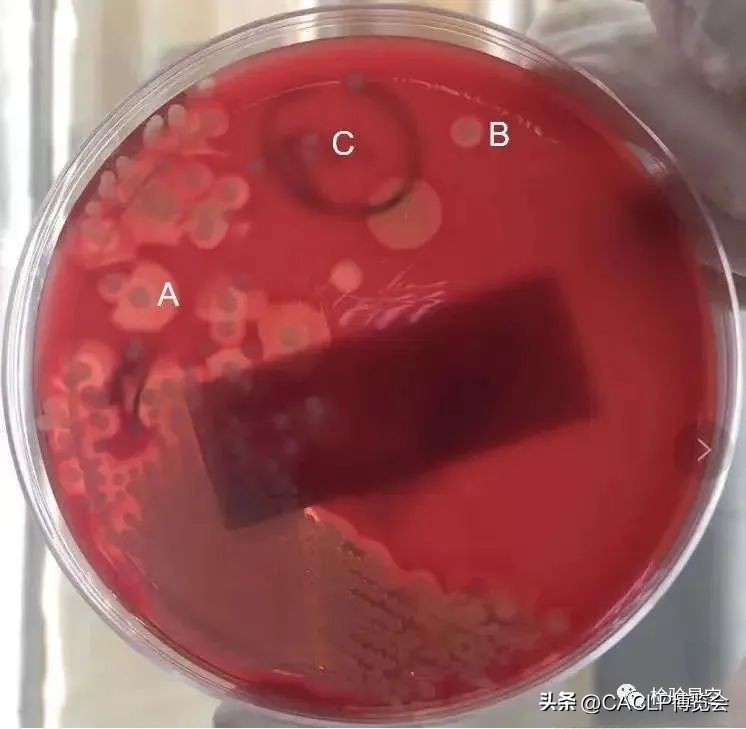
2017版医疗器械分类目录对照表,17年医疗器械分类目录21类
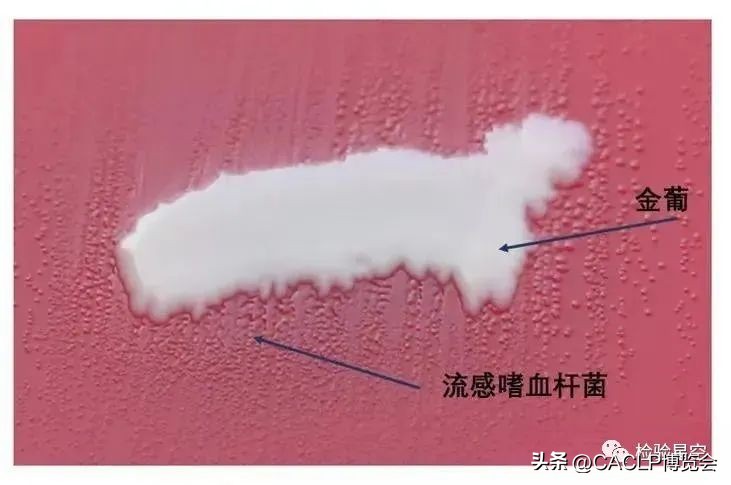
2017版医疗器械分类目录对照表,17年医疗器械分类目录21类

01铜绿假单胞菌
铜绿假单胞菌(P.Aeruginosa)原称绿脓杆菌。在自然界分布广泛,为土壤中存在的最常见的细菌之一。各种水、空气、正常人的皮肤、呼吸道和肠道等都有此菌存在。本菌存在的重要条件是潮湿的环境。
形态特征:
菌体细长且长短不一,有时呈球杆状或线状,成对或短链状排列。菌体的一端有单鞭毛,在暗视野显微镜或相差显微镜下观察可见细菌运动活泼。
培养鉴别:
为专性需氧菌,最适生长温度为25~30℃,特别是该菌在4℃不生长而在42℃可以生长的特点可用以鉴别。在普通培养基上可以生存并能产生水溶性的色素,如绿脓素(pyocynin)与带荧光的水溶性荧光素(pyoverdin)等。在血平板上会有透明溶血环。
临床表现:
为条件致病菌,是医院内感染的主要病原菌之一。患代谢性疾病、血液病和恶性肿瘤的患者,以及术后或某些治疗后的患者易感染本菌。
常引起术后伤口感染,也可引起褥疮、脓肿、化脓性中耳炎等。本菌引起的感染病灶可导致菌血症和败血症。烧伤后感染了铜绿色假单胞菌可造成死亡。
天然耐药:
氨苄西林、阿莫西林、阿莫西林/ 克拉维酸、第1代头孢菌素、第2代头孢菌素、头孢噻肟,头孢曲松,萘啶酸,甲氧嘧啶
02鲍曼不动杆菌
鲍曼不动杆菌属于非发酵革兰阴性杆菌中假单胞菌目莫拉菌科的不动杆菌属,本菌革兰染色阴性,不发酵糖类(麦康凯上为无色菌落),氧化酶阴性。
形态特征:
有荚膜、菌毛,无芽孢和鞭毛。镜下菌体多为球杆状,常成双排列,看似双球菌(常被误认为奈瑟属细菌),有时不易脱色(常误认成阳性球菌,但一般菌体着色不均,可用于鉴别)。
培养鉴别:
鲍曼不动杆菌有较强的粘附力,易于附着于物体表面。最适生长温度为35度,有些菌株可在42度生长。抵抗力强,在干燥的物体表面可存活25天,远远超过其他革兰阴性杆菌。
临床表现:
鲍曼不动杆菌在医院环境中分布广泛且在环境中可以长期存活,易在住院患者皮肤、结膜、口腔、呼吸道、胃肠道及泌尿生殖道等部位定植,极易造成危重患者的感染。
该菌主要引起呼吸道感染,也可引发菌血症、泌尿系统感染、继发性脑膜炎、手术部位感染以及呼吸机相关性肺炎等。
天然耐药:
氨苄西林、阿莫西林、第1代头孢菌素
03肺炎链球菌
肺炎链球菌为革兰染色阳性,菌体似矛头状,成双或成短链状排列的双球菌,有毒株菌体外有化学成分为多糖的荚膜。5%~10%正常人上呼吸道中携带此菌。有毒株是引起人类疾病的重要病原菌。
形态特征:
肺炎链球菌革兰染色呈阳性,直径约1μm。常呈双排列。菌体成矛头状,宽端相对,尖端向外。在痰、脓液标本中可呈单个或短链状。有毒株在体内形成荚膜。普通染色时荚膜不着色,表现为菌体周围透明环。无鞭毛,不形成芽胞。
培养鉴别:
本菌营养要求较高,需在含血液或血清的培养基中生长。在固体培养基上形成小圆形、隆起、表面光滑、湿润的菌落。培养初期菌落隆起呈穹窿形,随着培养时间延长,细菌产生的自溶酶裂解细菌,使菌落中央凹陷,边缘隆起成"脐状"。表面活性剂如胆汁或脱氧胆酸盐可激活自溶酶,加速菌体自溶。
兼性厌氧,C02 5-10%生长最好,且生成的菌落周围有草绿色溶血环。若于液体培养基中培养24h,呈均匀混浊,后期可因产生自溶而变得澄清。
临床表现:
肺炎链球主要引起人类大叶性肺炎。75%的成年人肺炎链球菌肺炎及50%以上严重的肺炎链球菌菌血症是由1~8型肺炎链球菌引起。肺炎链球菌6、14、19及23型,常引起儿童肺炎链球菌性疾病。40%~70%的正常人上呼吸道中携带有毒力的肺炎链球菌。
当出现某种降低这种抵抗功能的因素时,肺炎链球菌可引起感染,如呼吸道功能异常、循环系统功能异常及任何原因导致的肺充血、心功能衰竭等。
天然耐药:
甲氧嘧啶、氨基糖苷类抗生素

04大肠埃希菌
大肠埃希菌属于肠杆菌目肠杆菌科埃希菌属,是埃希菌属的代表菌种,常习惯称为大肠杆菌,是人和动物肠道的正常寄生菌,也是构成肠道正常菌群的主要部分。
形态特征:
为革兰阴性杆菌,两端钝圆粗短,大小为1.1~1.5μm × 2~6μm,多数有周鞭毛。
培养鉴别:
兼性厌氧,对营养要求不高。在麦康凯平板上形成红色、圆形隆起的菌落;在血琼脂平板上通常形成圆形、稍凸、边缘整齐、灰白色、不透明的光滑、湿润菌落,少数菌株产生β-溶血环,少数呈黏液型菌落或较大、扁平、皱起的粗糙型菌落。
临床表现:
在某些条件下,大肠埃希菌可以成为条件致病菌,比如有异物的存在(如导尿管)、宿主损伤或正常无菌部位的破损引起了粪便或高浓度混合菌的侵入。根据病原性大肠埃希菌是否在肠道内,将其大致分为两类:肠外致病性大肠埃希菌和肠内(或致泻性)大肠埃希菌。
肠外致病性大肠埃希菌存在多种毒力基因,产生黏附素、保护素、毒素等毒力因子,引起肠道外疾病。主要引起尿路感染,还可引起胆囊炎、新生儿脑膜炎、医院获得性肺炎、菌血症、脓毒症等,常见于腹腔内脓肿、肠穿孔继发腹膜炎、肠道手术后继发感染或大面积灼伤创面感染。
天然耐药:
克林霉素、达托霉素、夫西地酸、利奈唑胺、利福平、大环内酯类、糖肽类和脂肽类抗菌药物
05金黄色葡萄球菌
金黄色葡萄球菌 (Staphylococcus aureus ) 是人类的一种重要病原菌,隶属于葡萄球菌属(Staphylococcus),有"嗜肉菌"的别称,是革兰氏阳性菌的代表,可引起许多严重感染。
形态特征:
典型的金黄色葡萄球菌为球形,直径0.8μm左右,显微镜下排列成葡萄串状。革兰阳性菌,无芽孢、无鞭毛,体外培养时一般不形成荚膜,但少数菌株的细胞壁外层可见有荚膜样粘液物质。在某些化学物质(青霉素)作用下,可裂解或变成L型。
培养鉴别:
金黄色葡萄球菌营养要求不高,在普通培养基上生长良好,需氧或兼性厌氧,最适生长温度37℃,最适生长pH7.4。平板上菌落厚、有光泽、圆形凸起,直径1-2mm。血平板菌落周围形成透明的溶血环。
金黄色葡萄球菌有高度的耐盐性,可在10%-15%NaCl肉汤中生长。可分解葡萄糖、麦芽糖、乳糖、蔗糖,产酸不产气。
甲基红反应阳性,VP反应弱阳性。许多菌株可分解精氨酸,水解尿素,还原硝酸盐,液化明胶。在干燥环境中存活数月;空气中存在,但不繁殖。
耐热性强,加热70℃1h,80℃30min不被杀死;耐低温,在冷冻食品中不易死亡;耐高渗,在含有50%-66%蔗糖或15%以上食盐食品中才可被抑制,能在15%NaCl和40%胆汁中生长。金黄色葡萄球菌具有较强的抵抗力,对磺胺类药物敏感性低,但对青霉素、红霉素等高度敏感。
临床表现:
金黄色葡萄球菌是人类化脓感染中最常见的病原菌,可引起局部化脓感染,也可引起肺炎、伪膜性肠炎、心包炎等,甚至败血症、脓毒症等全身感染。其致病力强弱主要取决于其产生的毒素和侵袭性酶:
天然耐药:
氨曲南、多粘菌素E、萘啶酸
图片
06流感嗜血杆菌
流感嗜血杆菌是一种没有运动力的革兰氏阴性杆菌,于1892年由费佛博士在流行性感冒的瘟疫中发现,最初被误认为是流行性感冒的病因。
形态特征:
G-短小杆菌,大小为(0.3-0.4)×1.5μm,两端钝圆,无鞭毛,无芽孢,粘液型菌落有荚膜。
培养鉴别:
需氧,在5%-10%的二氧化碳环境下可促进生长,生成需要Ⅹ、V两种因子,最适宜的培养基是巧克力琼脂平板。
在巧克力琼脂平板上35℃培养18-24h形成微小、无色透明、似露滴状的菌落,且有鼠臭味;培养48h菌落直径可达1.5mm,培养72h后,菌落直径可达3-4mm,在血琼脂平板上金黄色葡萄糖周围形成极小、圆形、透明的菌落,并有“卫星现象”,有些菌株可产生黏液型菌落。
临床表现:
流感嗜血杆菌是细菌性肺炎较为常见的病原之一,高发于低龄儿童及春冬交替之际。
流感嗜血杆菌感染会引起寄生部位发生炎症,导致肺炎、化脓性脑膜炎、中炎、鼻窦炎、菌血症等疾病。不同疾病严重程度不一,其中,脑膜炎是流感嗜血杆菌感染导致的最严重疾病,病死率较高且容易导致严重的后遗症。
天然耐药:青霉素、红霉素、克林霉素